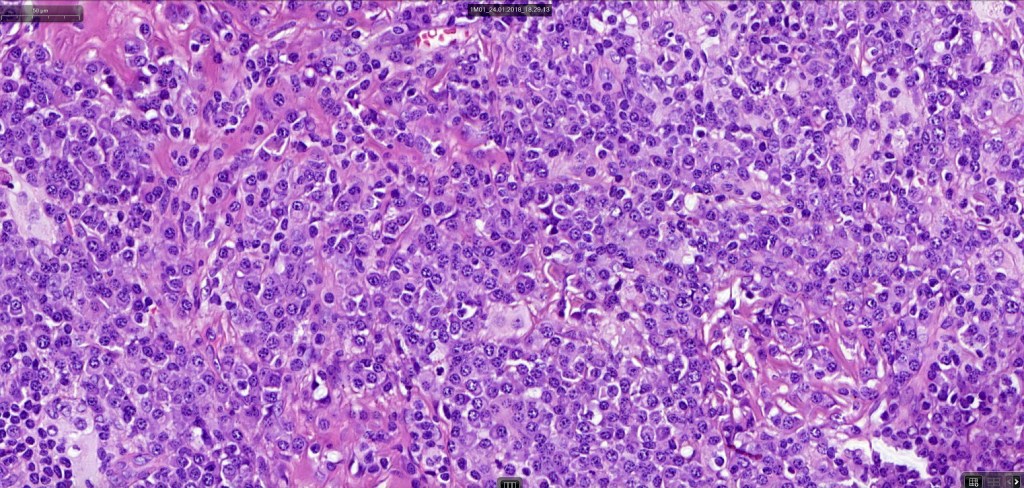
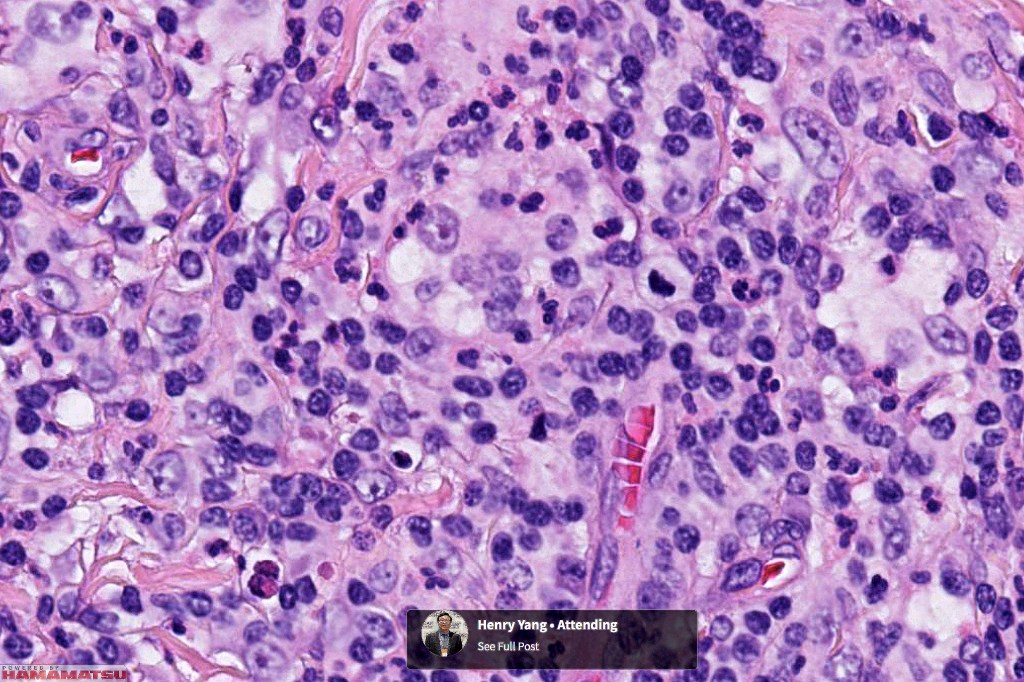
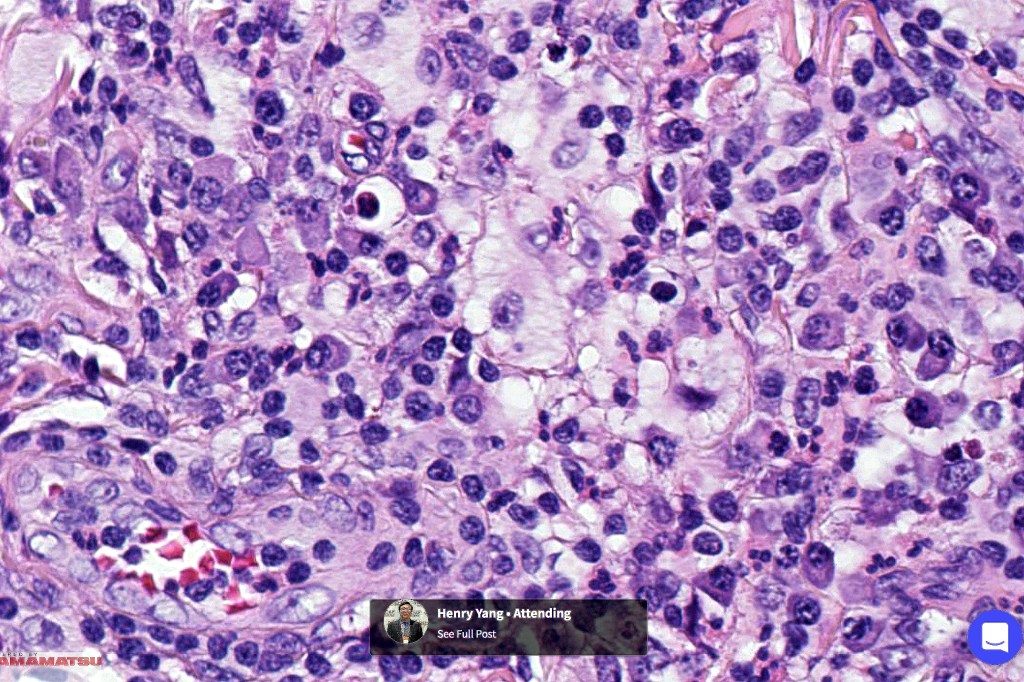
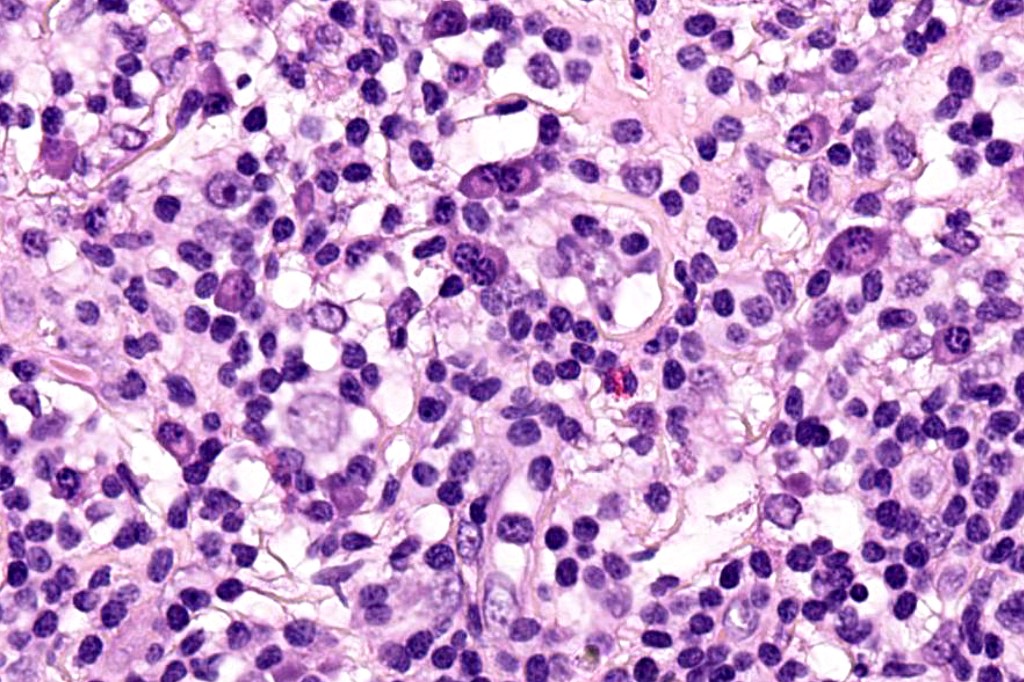
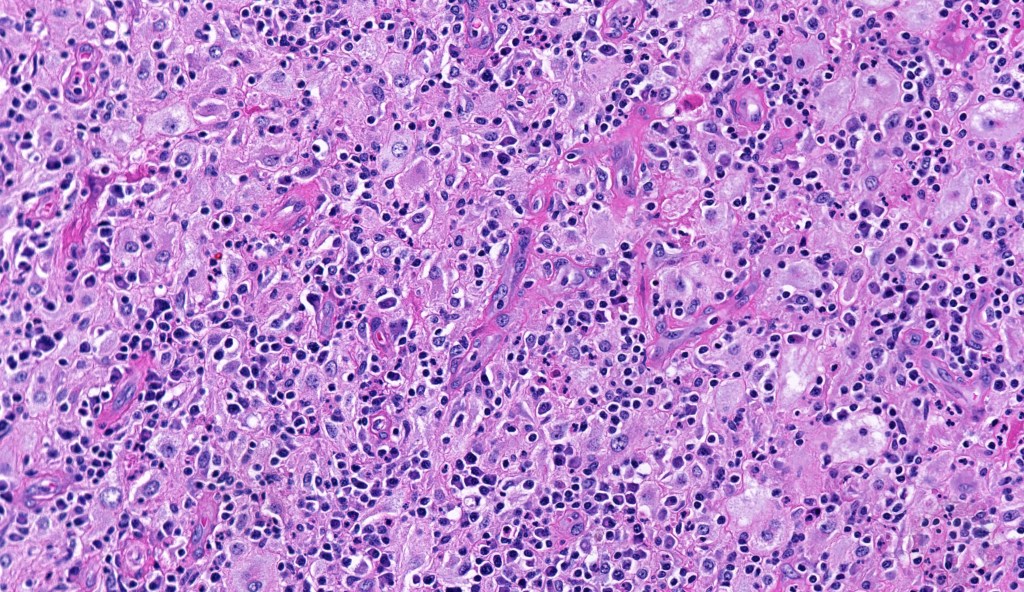
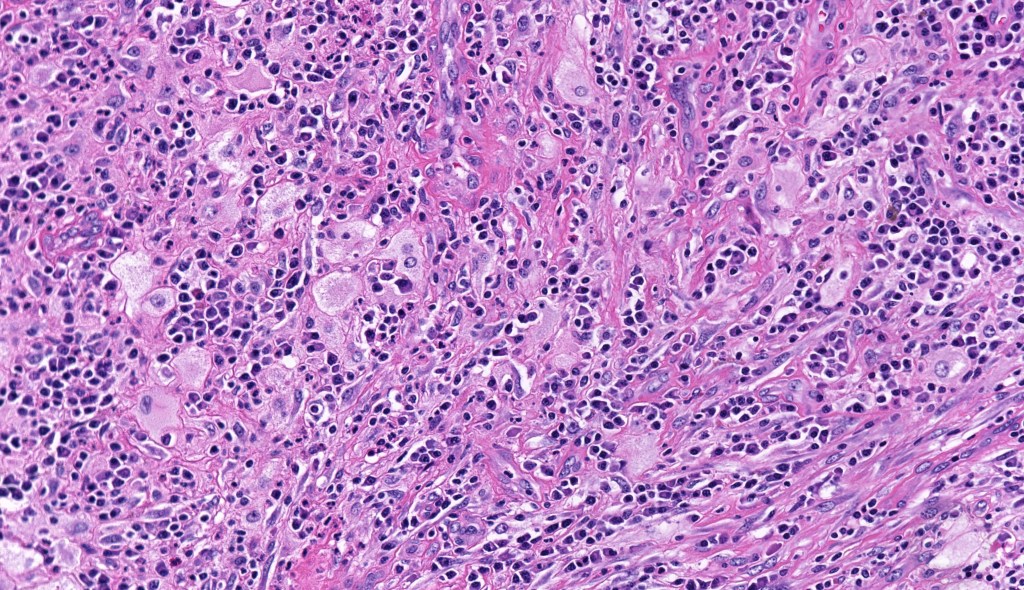
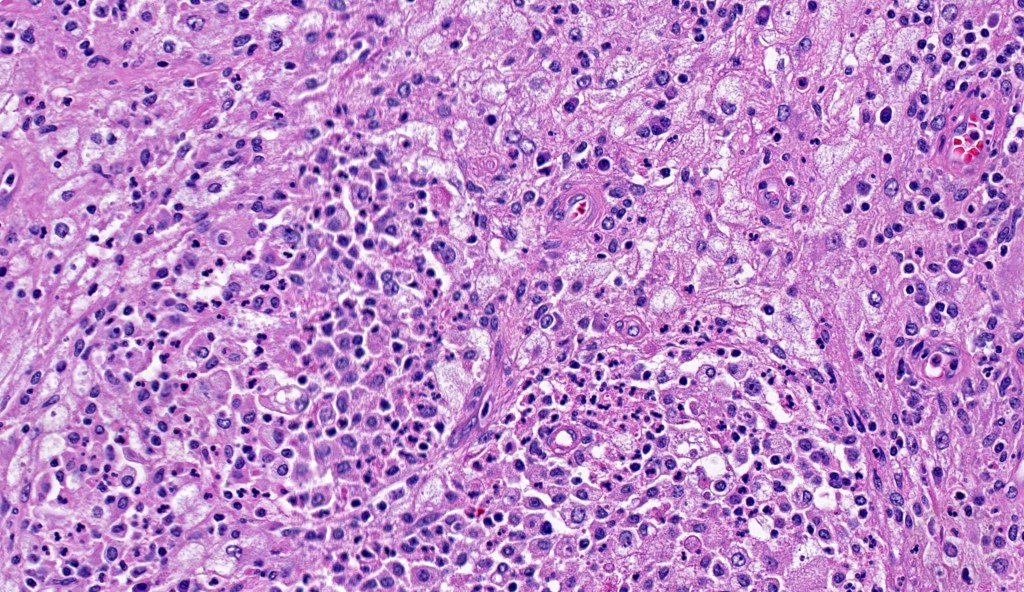
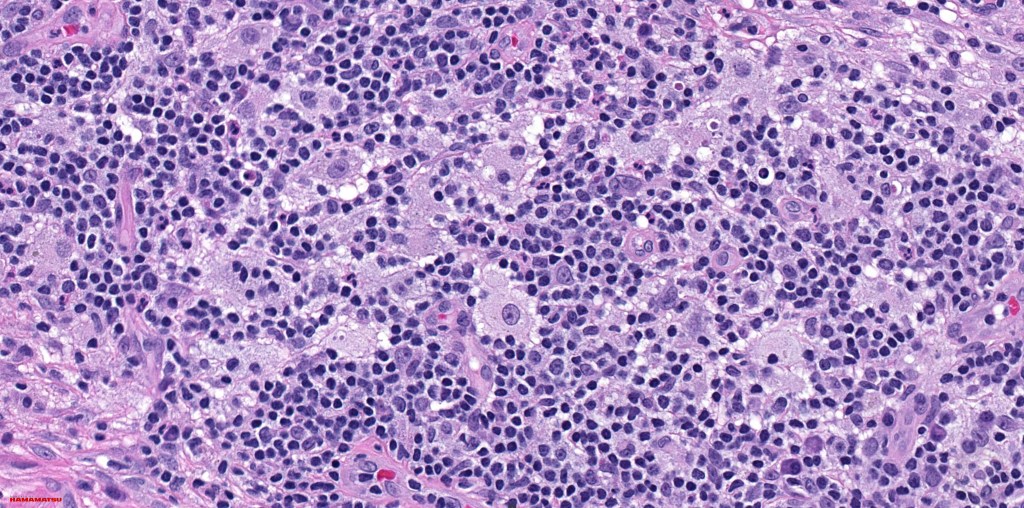
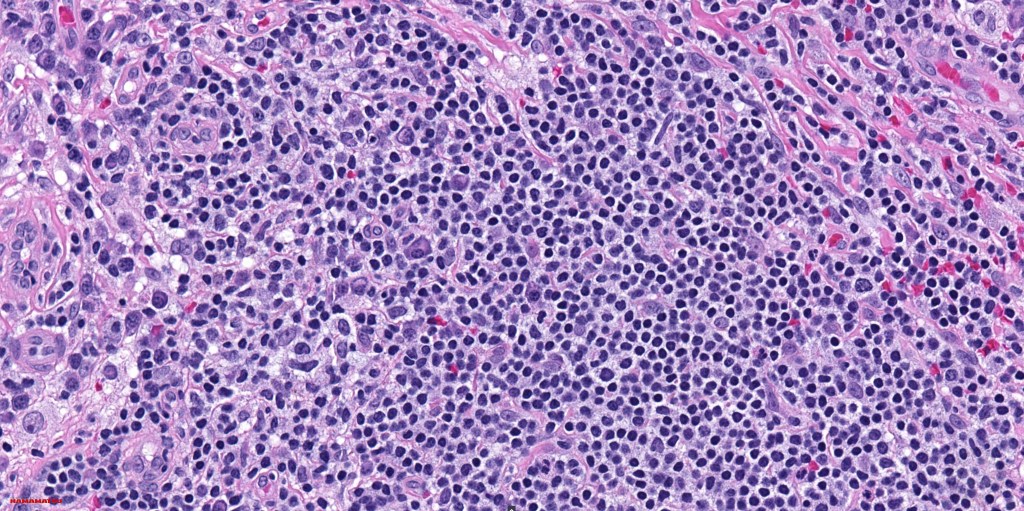
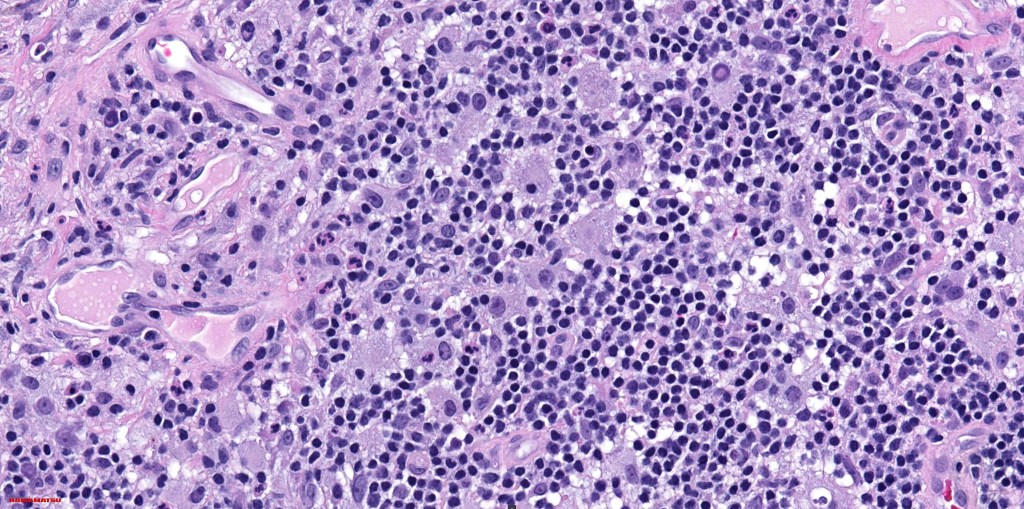
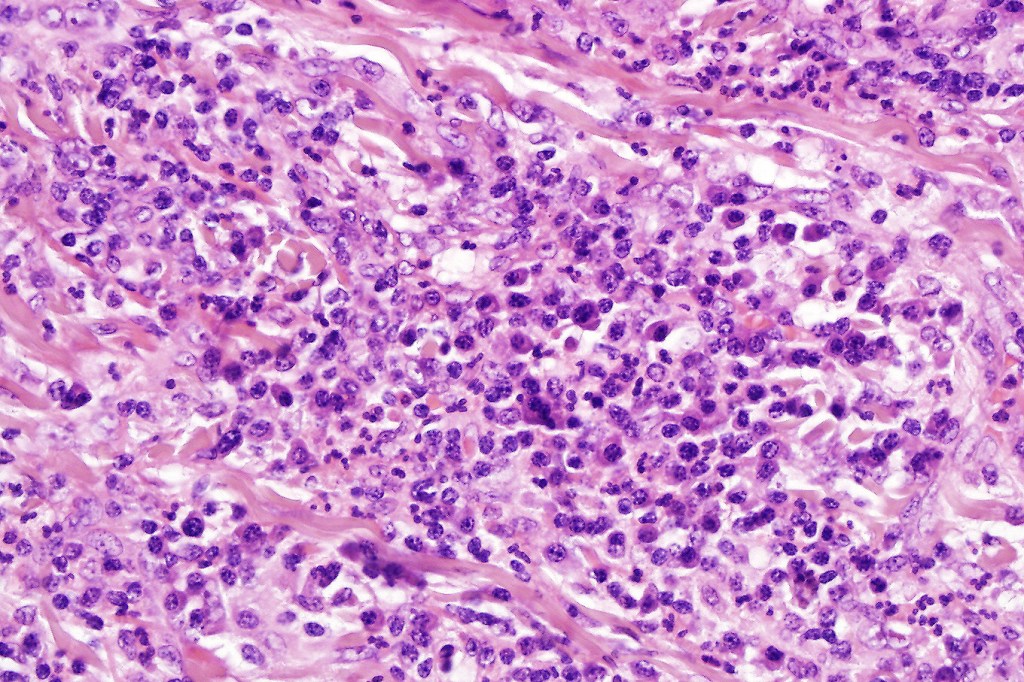
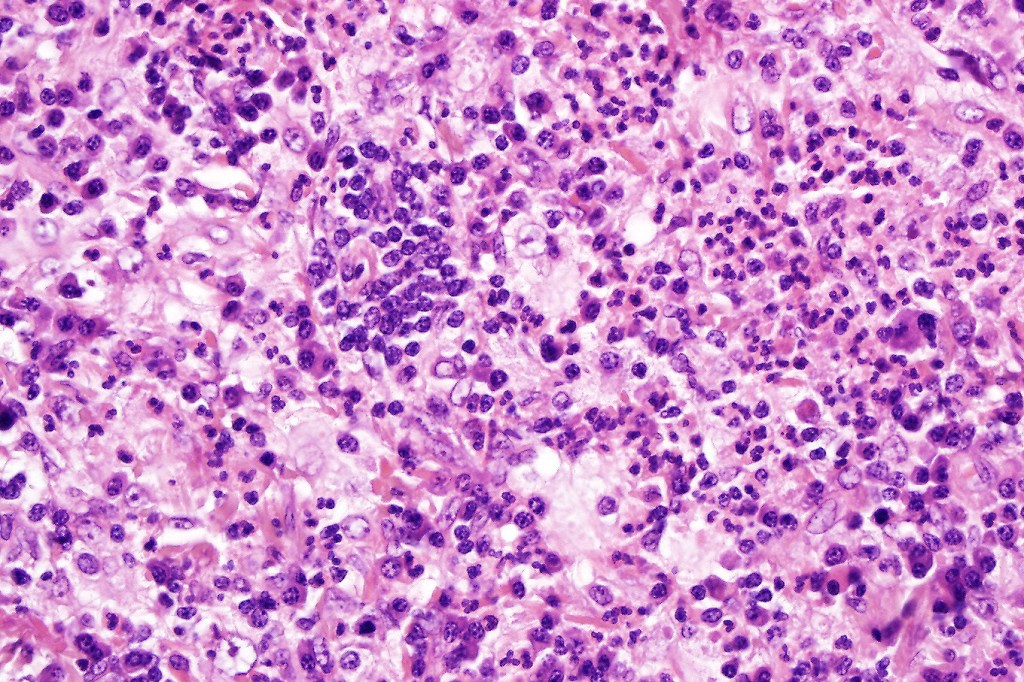
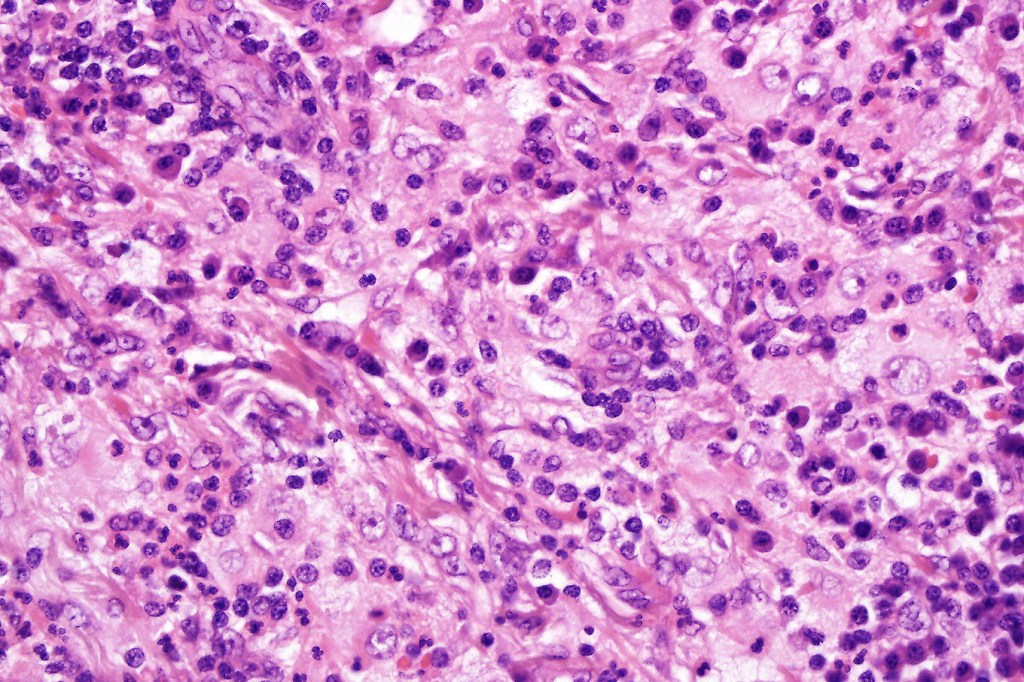
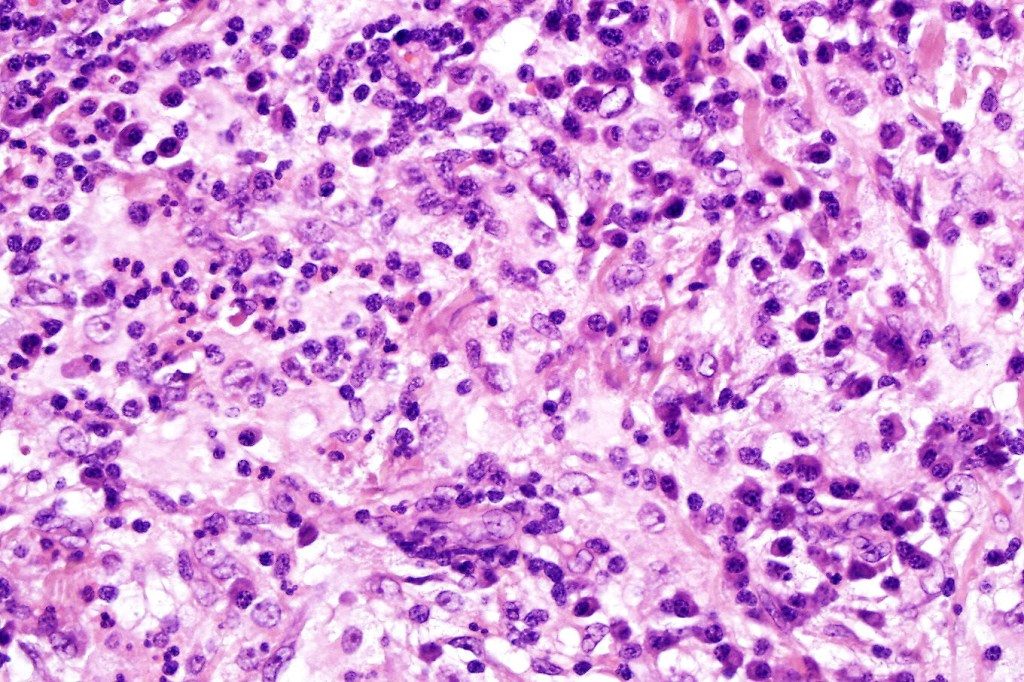
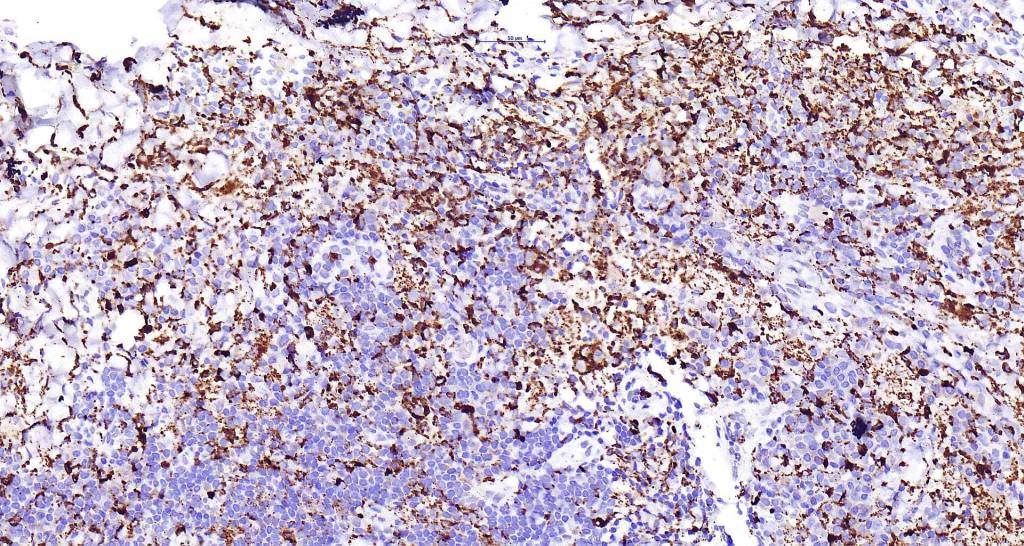

Clinical featues
•Primary cutaneous disease is very rare (3% of patients with Rosai Dorfman disease)
•Benign, self limiting
•Skin is commonly involved in patients with nodal disease (10%)
•Primary cutaneous disease is more common in middle aged patients & shows a female predominance
•Mostly White & Asian populations
•Lesions are generally multiple, polymorphic and include papules, nodules or plaques variably flesh colored, pink, red-brown or yellow
•Limbs, trunk & face but may occur anywhere
•Most patients develop spontaneous remission
•Exceptional recurrence



Histological features
•Generally, a polyclonal histiocytic proliferation although a subset are clonal
•Subset associated with NRAS mutations
•BRAFV600E mutation absent
•Possible association with IgG4-related sclerosing diseases
•Due to the admixture of pale histiocytes and lymphocytes, the scanning view is characteristic, and the diagnosis can be strongly suspected at this magnification
•Dense dermal nodular infiltrate sometimes extending into subcutaneous fat
•Histiocytes are large with irregular borders and abundant cytoplasm
• Vesicular nuclei with a prominent nucleoli
•Emperipolesis of lymphocytes, plasma cells & neutrophils
•Background population of lymphocytes, plasma cells, neutrophils, eosinophils & variable numbers of xanthoma cells
•Lymphoid follicles with germinal centers sometimes present
•Fibrosis is occasionally conspicuous
•Exceptional co-existent Langerhans cell histiocytosis
•Histiocytes are S100, CD68 & CD163 +ve
.CD1a & langerin -ve

Differential diagnosis
The only real differential diagnosis is distinction between nodal disease secondarily affecting the skin & primary cutaneous lesions. Clinicopathological correlation is essential.
Leave a comment